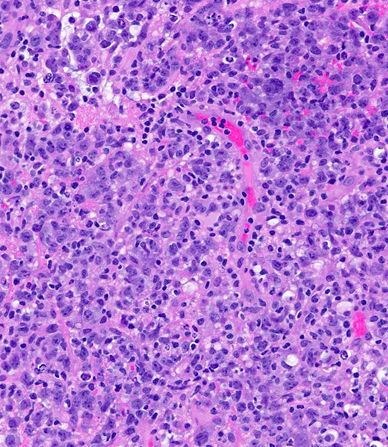

October 2022
Authors
Lauren Moshea, DO (Resident), Serguei I. Bannykh (Faculty), Jethro Hu, MD (Faculty)
Neuropathology
Clinical History
A male patient in his 40s presented to outside hospital after developing left facial droop, slurred speech and urinary incontinence while traveling. The medical history was remarkable for Tdap vaccination administered three days prior to the commencement of his symptoms. MRI of the brain and spinal cord showed multifocal enhancing confluent white matter lesions. He was diagnosed with acute disseminated encephalomyelitis (ADEM). He was subsequently started on high-dose steroids (solumedrol 1 gram) daily x five days followed by a steroid taper. After returning home he presented to Cedars-Sinai ED one month later with similar symptoms of worsening slurred speech and altered gait. He was again started on steroids with improvement of his symptoms and was discharged home but was admitted again two weeks later with worsening symptoms. MRI imaging showed multifocal supratentorial and infratentorial parenchymal T2/FLAIR signal abnormality involving the cerebral hemispheres, deep gray/white matter, corpus callosum (splenium) and brainstem white matter tracts, raising suspicion for neoplastic process [left image, upper panel]. He was placed on IVIG (2 grams/kg) over five days and was continued on prednisone 60 milligrams daily. Serum autoimmune encephalopathy panel, NMO and MOG cell-based assays were all negative. Ultimately, he underwent a brain biopsy which showed involvement by diffuse large B-cell lymphoma [right image]. It was BCL6 rearranged by FISH while NGS identified mutations in CDKN2A, PIM1, CD79B, CTCF, ATM and SOCS1.

Clinical Treatment
He was treated with three cycles of methotrexate (dose 7.6 grams/m2), two cycles of temozolomide (80 milligrams for five days on and 23 days off), and rituximab and achieved clinical remission. MRI showed complete resolution of mass lesions [left image, lower panel]. He subsequently underwent conditioning chemotherapy with carmustine (400 milligrams/m2)/ thiotepa (5 milligrams/kg q12 hours x two days) followed by and autologous stem cell transplant (total of 3.97x106/kilograms CD34+ cells infused).
Discussion
Central nervous system diffuse large B-cell lymphoma accounts for <1% of all non-Hodgkin lymphomas and ~3% of all brain tumors. Primary diffuse large B-cell lymphoma (DLBCL) of the CNS is defined as DLBCL arising within the brain, spinal cord, leptomeninges or eye. Primary diffuse large B-cell lymphoma of the CNS excludes lymphomas of the dura, intravascular large B-cell lymphomas, lymphomas with evidence of systemic disease or secondary lymphomas, and all immunodeficiency-associated lymphomas. In immunocompetent individuals the etiology of this disease is unknown. Patients usually present with cognitive dysfunction, psychomotor slowing and focal neurologic symptoms. For detecting CNS DLBCL, magnetic resonance imaging (MRI) is the most sensitive technique. The gold standard for establishing diagnosis is a stereotactic biopsy with microscopic review showing highly cellular diffusely growing large cells. On immunohistochemistry the tumors are PAX5+, CD19+, CD20+, CD22+, CD79a+, and kappa or lambda light chain restricted. In addition, most cases express BCL6 as well as MUM1. Prognosis is worse in patients with CNS DLBCL than patients with systemic DLBCL. Other negative prognostic factors include older age (>65 years) and del(6)(q22). Currently the treatment of choice for these patients is high-dose methotrexate-based polychemotherapy. With treatment the median progression-free survival is 12 months with the overall survival rate being approximately three years. Lastly, some sporadic systemic relapses have been observed with the most frequent relapses involving the testis and breast.
References
- Baraniskin A, Deckert M, Schulte-Altedorneburg G, Schlegel U, Schroers R. (2012). Current strategies in the diagnosis of diffuse large B-cell lymphoma of the central nervous system. British Journal of Haematology, 156(4), 421–432. https://doi.org/10.1111/j.1365-2141.2011.08928.x
- Bhagavathi S, Wilson JD. (2008) Primary central nervous system lymphoma. Archives of Pathology & Laboratory Medicine, 132, 1830–1834.
- Swerdlow SH, Campo E, Thiele J, Stein H, Pileri SA, Jaffe ES, Harris NL. (2017). Primary diffuse large B-cell lymphoma of the CNS. In WHO classification of tumours of haematopoietic and lymphoid tissues (4th ed., pp. 300–302) essay, International Agency for Research on Cancer.